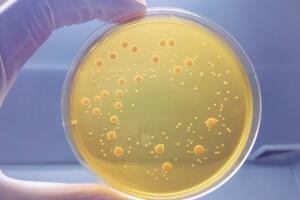
bacterias_1.jpg

nuevos descubrimientos
nuevos descubrimientos: Últimas noticias, videos y fotos de nuevos descubrimientos
- article2 Min ReadAugust 05, 2020 04:40 PMInvestigadores de la Universidad Nacional Autónoma de México (UNAM) encontraron un exoplaneta en forma de gigante gaseoso con un método muy poco usual en la astronomía.
- article2 Min ReadAugust 04, 2020 11:56 AMNo todos los cuerpos estelares son descubiertos por astrónomos especializados, pues un par de estudiantes adolescentes descubrieron un asteroide que se dirige a la Tierra.
- article2 Min ReadJuly 31, 2020 11:45 AMUn nuevo estudio genético sugiere que los neandertales pudieron tener una adaptación evolutiva, de la cual carecen la mayoría de humanos actuales.
- article1 Min ReadJuly 29, 2020 04:11 PMAstrónomos encontraron señales de una estrella muerta por primera vez en la Vía Láctea que podrían ayudar a resolver misterios del Universo.
- article1 Min ReadJuly 27, 2020 02:53 PMCientíficos hicieron un descubrimiento accidental de dos bacterias que podrían resolver preguntas de hace más de 100 años.
- article2 Min ReadJuly 23, 2020 04:29 PMCientíficos captaron por primera vez en video el proceso de eliminación de las neuronas muertas en el cerebro y es un avance para encontrar una cura a enfermedades cognitivas.
- article2 Min ReadJuly 22, 2020 04:17 PMNo se trata de un monstruo marino como el del Lago Ness, pero descubrieron una nueva especie acuática que absorbe grandes cantidades de luz gracias a sus extrañas características.
- article2 Min ReadJuly 22, 2020 12:38 PMLa ciencia podría estar cerca de encontrar una forma para alargar la vida de las personas gracias al hallazgo de los mecanismos responsables del envejecimiento en la células.
- article1 Min ReadJuly 21, 2020 05:07 PMLa familia del Tiranosaurio Rex no siempre fue gigante y temible: uno de sus ancestros era diminuto, pero igual de feroz.
- article1 Min ReadJuly 21, 2020 04:30 PMYutu-2, el robot chino que exploró la Luna por más de tres meses, encontró una rara sustancia que tiene intrigados a los científicos.